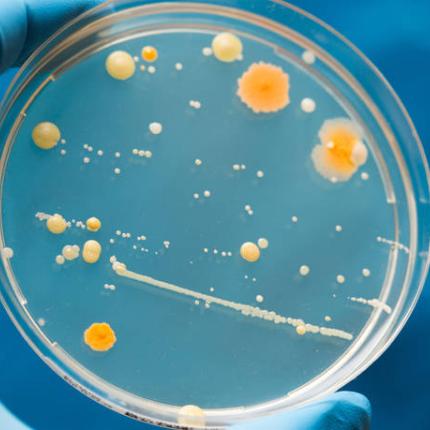
mikitas.jpg

Ο δυνητικά επικίνδυνος μύκητας Candida auris...
Κενά που παρατηρούνται στην εμβολιαστική κάλυψη κατά της ιλαράς οδήγησαν σε επιδημίες της εξαιρετικά μετα
Οι γαλλικές αρχές διέταξαν σήμερα τη μαζική εξόντωση πουλιών σε τρεις περιοχές που έχουν πληγεί περισσότερο από την τελευτ
Τουλάχιστον 13 άνθρωποι έχασαν τη ζωή τους από χολέρα στη νοτιοδυτική Αϊτή μετά τις καταστροφές που προκάλεσε το πέρασμα τ
Η επιδημία ιλαράς στο νοτιοανατολικό τμήμα της Λαϊκής Δημοκρατίας του Κονγκό έχει στοιχίσει τη ζωή 428 ανθρώπων και έχει μ
Μια νέα επιδημία αποχρωματισμού των κοραλλιών βρίσκεται σε εξέλιξη και επεκτείνεται στις θάλασσες της Γης, προειδοποιούν ο
Παρά τη σημαντική μείωση των νέων κρουσμάτων του ιού Έμπολα, η κατάσταση παραμένει «εξαιρετικά ανησυχητική» στις...
Ο αριθμός των νεκρών από το χειρότερο ξέσπασμα επιδημίας Έμπολα στην ιστορία έχει φτάσ
Ο Παγκόσμιος Οργανισμός Υγείας (ΠΟΥ) ανακοίνωσε την εμφάνιση πανώλης στη Μαδαγασκάρη και προειδοποίησε για τον κίνδυνο η ε
Ο αριθμός των κρουσμάτων του ιού Έμπολα έχει μειωθεί στη Λιβερία, τη χώρα που έχει πληγεί περισσότερο από την επιδ
Ο ηγέτης της Κούβας Φιντέλ Κάστρο πρότεινε σήμερα στις Ηνωμένες Πολιτείες συνεργασία για την αντιμετώπιση του ιού...